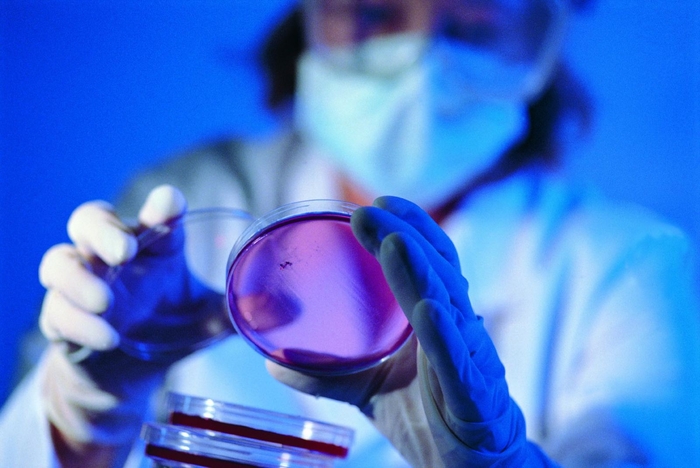
В США узнали, как уйти от презервативов В США узнали, как уйти от презервативов
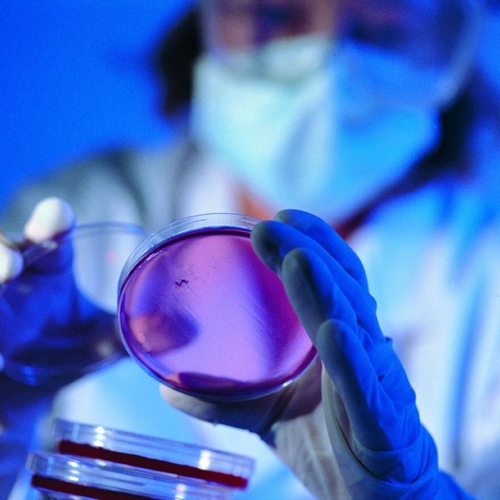

Не давать созреть сперматозоидам - и можно забыть о резинках: M PORT узнал о новом методе контрацепции из Америки
Американские ученые из Центра медицинских исследований (Нью-Йорк) нащупывают свой вариант эффективной контрацепции для мужчин. Для этого они активно задействовали крыс.
В США узнали, как уйти от презервативов
cclg.org.uk
Результаты недавно завершенных исследований опубликованы в журнале Nature Communications. В отчете говорится о том, что группе микробиологов удалось временно затормозить процесс формирования активных половых клеток. Чтобы добиться такого результата, в организм подопытных животных вводился синтетический аналог особого белка, который получил название пептид F5.
ЧИТАЙ ТАКЖЕ: Мужская пилюля: резинкам скоро конец
Роль данного протеина – адекватное регулирование работы гематотестикулярного барьера, который формируется в семяпроводящих канальцах. Иными словами, пептид F5 «закрывает» канальцы означенным барьером и не дает выходить сперматозоидам, пока они не созрели для оплодотворения женской яйцеклетки.
Поступлением в мужской организм дополнительного количества белка американские ученые добились того, что барьер в канальцах стал открываться раньше положенного времени, давая таким образом возможность выхода для сперматозоидов, не достигших зрелости.

В США узнали, как уйти от презервативов
renishaw.com
На данный момент разработчики нового метода контрацепции видят в нем, как минимум, три потенциальных преимущества. Во-первых, он дает возможность не пользоваться презервативами, что делает секс более полноценным.
Во-вторых, эксперименты на крысах показали, что процесс «снятия барьеров» обратим – стоит только прекратить дополнительное поступление пептида F5 в организм, как в канальцы начинает снова поступать только половозрелая семенная жидкость. И наконец, что очень важно для здоровья, так как названный белок вырабатывается самим мужским организмом, то он, скорее всего, будет хорошо им переноситься.
ЧИТАЙ ТАКЖЕ: Супер-гель: чем заменить презерватив
Впрочем, ученые предостерегают тех, кто уже засобирался в аптеку закупать препараты на основе пептида F5. Исследования пока не закончены, и потому еще ничего нельзя окончательно гарантировать, говорят эксперты Центра медицинских исследований.
Это интересно